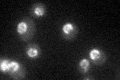
YDL088C
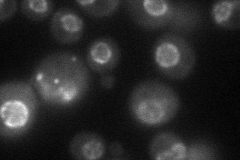
YDL088C
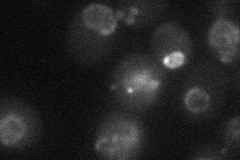
YDL088C
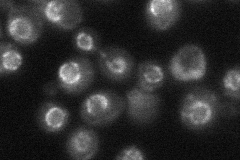
YDL088C

View description
Nuclear pore complex subunit, part of a subcomplex also containing Nup53p, Nup170p, and Pse1p
Localization:
Intensity:
Fold change:
Significance:
-
C’ GFP library in SD
nuclear periphery39.34 -
N' NOP1pr-GFP in SD
punctate,nuclear periphery52.3544 -
N' TEF2pr-mCherry in SD
punctate,nuclear periphery18.0627 -
N' NATIVEpr-GFP in SD
punctate,nuclear periphery27.6018 -
N' TEF2pr-VC and Cyto-VN in SD

#N/A0 -
C’ GFP library in SD+DTT

nuclear periphery26.10.66Yes -
C’ GFP library in SD+H2O2

nuclear periphery37.860.96No -
C’ GFP library in Starvation Media

nuclear periphery51.191.3No -
C’ GFP library on the background of Pup2-DaMP

nuclear periphery -
C’ GFP library on the background of CCT mutant

nuclear periphery30.57860.777251No
